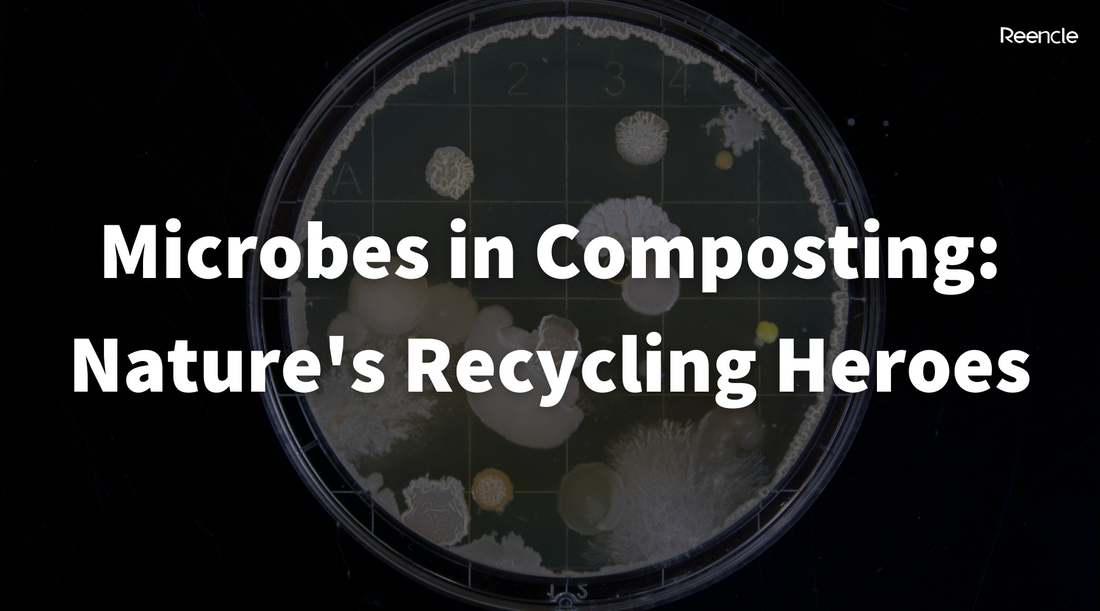
Microbes in Composting: Nature's Recycling Heroes

Composting, often regarded as the unsung hero of waste management, is a natural process that transforms organic materials into nutrient-rich soil amendment. At the heart of this transformation are microbes — tiny, invisible organisms that play a pivotal role in breaking down complex organic matter.
In this article, we'll delve into the world of microbes, exploring what they are and why they are indispensable in the composting process.
Microbes Unveiled: The Invisible Workforce
Microbes, short for microorganisms, are microscopic living entities that include bacteria, fungi, protozoa, and algae. Found virtually everywhere on Earth, these tiny organisms are the unsung heroes of the natural world, orchestrating processes that sustain life. In the context of composting, bacteria and fungi take center stage.

Bacteria: The Decomposers
Bacteria are single-celled organisms that exist in diverse shapes and sizes. In composting, they are the primary decomposers, breaking down complex organic compounds into simpler substances. Specifically, two types of bacteria—aerobic and anaerobic—contribute to the composting process.
Aerobic Bacteria
These oxygen-loving microbes thrive in the presence of oxygen. They are responsible for the initial stages of composting, breaking down easily degradable materials such as sugars, starches, and proteins. The metabolic activities of aerobic bacteria generate heat, a key factor in the composting process.
Anaerobic Bacteria
In the absence of oxygen, anaerobic bacteria take charge. While they are less efficient than their aerobic counterparts, anaerobic bacteria play a crucial role in decomposing tougher materials, like woody debris. However, anaerobic decomposition often produces unpleasant odors, emphasizing the importance of maintaining proper aeration in compost piles.
Fungi - Nature's Recyclers
Fungi, another group of microbes, include molds and yeast. They complement the work of bacteria by breaking down complex organic matter, such as cellulose and lignin, into simpler compounds. Fungi contribute to the creation of humus—a stable organic material that enhances soil structure and fertility.
One key feature of fungi in composting is the development of mycelium, a network of thread-like structures that extends through the compost pile. Mycelium acts as a sort of natural glue, binding together compost particles and creating a cohesive structure.

The Composting Symphony: Microbial Interactions
Composting is not a solitary endeavor; it's a microbial symphony where various organisms interact harmoniously. The process typically follows four phases:
Mesophilic Phase: The initial stage where mesophilic (moderate temperature) bacteria thrive, breaking down easily decomposable materials.
Thermophilic Phase: As the compost pile heats up, thermophilic (high-temperature) bacteria take over. This phase is crucial for killing weed seeds and pathogens, ensuring a safe and effective composting process.
Cooling Phase: As the pile cools, mesophilic bacteria return, along with fungi, to continue the decomposition process.
Maturation Phase: The final stage involves the maturation of the compost, during which the microbial activity decreases, and the compost becomes stable and ready for use.

Why Microbes Matter: The Benefits of Microbial Composting
Microbial activity in composting offers a plethora of benefits:
Accelerated Decomposition: Microbes significantly expedite the breakdown of organic matter, turning kitchen scraps and yard waste into nutrient-rich compost in a matter of weeks.
Nutrient Release: The microbial decomposition process releases essential nutrients, such as nitrogen, phosphorus, and potassium, making the resulting compost a valuable fertilizer for plants.
Pathogen and Weed Control: The heat generated by microbial activity during the thermophilic phase helps eliminate harmful pathogens and weed seeds, ensuring that the compost is safe for use in gardens.
Soil Structure Improvement: The byproducts of microbial decomposition, including humus and organic acids, enhance soil structure, water retention, and aeration.
Environmental Sustainability: Composting reduces the volume of organic waste sent to landfills, mitigating greenhouse gas emissions and contributing to a more sustainable waste management system.
Embracing the Microbial Magic
In the intricate dance of composting, microbes take center stage, performing the vital task of transforming organic waste into a valuable resource. Understanding and harnessing the power of these tiny organisms allows us to unlock the full potential of composting, promoting a sustainable and regenerative approach to waste management. As we embrace the microbial magic in composting, we not only enrich our soils but also contribute to a healthier planet for generations to come.
Reencle uses the gift of microbes in its composting process, too! Thanks to all the benefits of microbes in compost that we've gone over, Reencle is able to successfully turn your food waste into compost in 24 hours or less! Get a discount of RM400 when you sign up here today!